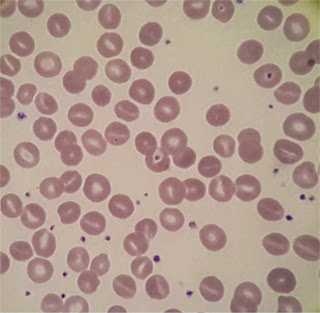

Stomatocytes
Created 6 December 2018. Last update 16 January 2021 (Incorporaed original page and Google Document to
new format)
What is a stomatocyte?
Stomatocytes are red cells. However rather than
having a circular central pallor, the centre of the cell appears slit-like
giving them the appearance of "coffee beans" or "kissing
lips".
However this might be misleading; the three
dimensional shape is more akin to a bowl. The usual biconcave morphology having
been lost due to a membrane defect which has led to an alteration in membrane
permeability. This causes an increase in red cell volume.
Stomatocytosis can be inherited or
acquired.
The hereditary form is often known as
Hereditary Xeroocytosis is a rare, autosomal dominant
congenital hemolytic anemia
characterized by macrocytic stomatocytosis, and
decreased red cell osmotic fragility due to a defect in cation permeability. The
mechanism of stomatocyte formation often involves
changes in cell volume caused by reduced intracellular ion content and
trans-membrane pump malfunction.
This defect results in dehydrated erythrocytes The clinical presentation
of which exhibits marked heterogeneity, ranging from supernormal hemoglobin values to severe anaemia.
Other inherited conditions causing stomatocytosis
include

Acquired stomatocytosis has been noted in cases of
• neoplasm
• cardiovascular disease
• hepatobiliary disease
• iron deficiency (as in this
case)
• acute alcoholism
Stomatocytes tend to form at a lower blood pH, as
seen in exposure to cationic detergents and in patients receiving phenolthiazine or chlorpromazine. (used in the treatment
of psychotic disorders)
In most cases of acquired stomatocytosis (and some rare inherited conditions)
there can be either a decrease in red cell membrane surface area or qualitative
changes in the composition of the membrane lipid bilayer (pumps again).
Bearing in mind though that that unless 10% or more of the RBC's are stomatocytes, their presence is probably artifactual
Some stomatocytes of my experience
November 2018
|
DUCK Lewis T M K1234567
03.04.56 Z,18.0009894.F R
24.01.18 Clinical details PANCREATIC CA --------------------------------------------------------------------------- HBM WBCM PLT
HCT RBCM MCVM
MCHM MCHCM RDW
N 210118 F 90 15.09
677 0.276 3.10
89.0 29.0 326
15.4 12.80 220118 F 91 14.77
603 0.277 3.10
89.4 29.4 329
15.8 12.32 230118 F 86 12.70
613 0.265 2.91
91.1 29.6 325
16.1 10.36 240118 F 90 13.86
589 0.277 3.03
91.4 29.7 325
16.4 11.11 L M E
B NUC NUCA
ESR GF 210118 F 1.06 1.01
0.16 0.06 0.0
0.00 220118 F 0.97 1.20
0.23 0.05 230118 F 1.08 1.07
0.14 0.05 240118 F 1.33 1.23
0.16 0.03 |
December 2018
Now this patient's blood count was classic iron deficiency - "normal"
(for want of a better term) a year ago. Now presenting with a
hypochromic microcytic anaemia there were several stomatocytes
seen. You don't see them very often; this was the third such patient today
Some More Expert Opinion…
An article from the nice people at Lablogatory
Low phosphate causing stomatocytosis